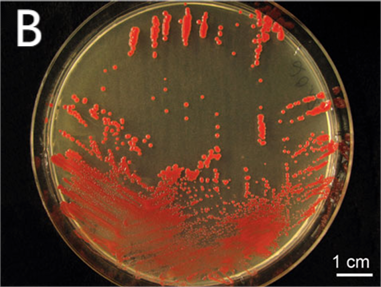

1.嗜中温甲基杆菌(Methylobacterium mesophilicum)
物种名:嗜中温甲基杆菌
拉丁学名:Methylobacterium mesophilicum
分类学地位:细菌界Bacteria;变形菌门Proteobacteria;
α-变形菌纲Alphaproteobacteria;嗜甲基菌目Methylophilales;
甲基杆菌科Methylobacteriaceae;甲基杆菌属Methylobacterium
嗜中温甲基杆菌(Methylobacterium mesophilicum)属于条件致病菌,常感染免疫功能底下以及儿童人群,它存在于环境中,已从叶子表面、土壤和污水中分离出来。感染该菌可引起尿毒症患者透析后的腹膜炎、皮肤溃疡、菌血症和其他感染等疾病。
1.1生物学特性
1.1.1培养特征
嗜中温甲基杆菌在血琼脂平板上35℃培养18-24小时形成较小、凸起、粉色的菌落,48小时后逐渐增大(图1A);在普通肉汤培养基上生长缓慢,可产生粉红色色素(图1B);在麦康凯平板上一般不生长[1]。
图1 嗜中温甲基杆菌在各种平板上的培养结果
A:血平板[1],B:肉汤培养基[2]
1.1.2形态学特征
嗜中温甲基杆菌为革兰氏阴性菌,整体为杆状、空泡状,具有一个极鞭毛[3]。

图2 嗜中温甲基杆菌显微照片[3]
1.1.3生化特征
嗜中温甲基杆菌可以分解木糖、海藻糖、阿拉伯糖,不分解果糖和甘露醇,氧化酶试验和动力试验阳性,枸橼酸盐和七叶苷试验阴性。不产生β-半乳糖苷酶、L-鸟氨酸脱羧酶、L-赖氨酸脱羧酶和L-精氨酸二水解酶[4]。
1.2分布、传播与致病性
1.2.1分布与传播
嗜中温甲基杆菌在自然界中无处不在,常见于植物、土壤、淡水、湖泊沉积物和医院环境中。本菌在水环境中可长期存在,可饮用水供应和医院自来水中分离,本菌在医院环境中的传播与受污染的自来水有关[5]。
1.2.2致病性
嗜中温甲基杆菌是在水和土壤中发现的人类机会性病原体,尽管毒力低,但甲基杆菌能够在免疫功能低下患者中引起定植和感染。感染该菌会引起轻微的临床症状,如发热、头晕等,但也可能会导致菌血症、腹膜炎和肺炎等。该菌常导致医源性爆发,这与该菌污染医院自来水后再杯用于清洗支气管镜和内窥镜等医疗器械有关。该菌具有很强的形成生物膜的能力,生物膜在不同的表面上形成,包括医疗设备、供水系统或内窥镜通道,它们极难去除,并允许微生物在干燥以及化学和抗生素暴露条件下存活,从而导致免疫力低下患者更容易患病[6]。
嗜中温甲基杆菌对阿米卡星、庆大霉素、环丙沙星和甲氧苄啶-磺胺甲噁唑敏感,对头孢曲松、头孢唑肟和亚胺培南高度敏感。碳青霉烯类药物敏感性不一致,对亚胺培南高度敏感和对美罗培南耐药,可能是甲基杆菌属的一个显著特征[7]。
1.3检测方法
- 传统方法:可采用细菌分离培养的方法对嗜中温甲基杆菌进行鉴定,将样本接种于血平板中进行分离培养,挑取单菌落进行显微镜镜检,最后进行生化特征鉴定,氧化酶试验和动力试验阳性,枸橼酸盐和七叶苷试验阴性等。
- 新型方法:近几年根据16S rRNA和宏基因组测序分析来鉴定菌种越发流行,本菌也可采用此方法进行鉴定。提取环境样本DNA后进行测序,测序结果与NCBI数据库中嗜中温甲基杆菌的序列进行比对,即可确定环境样本中该菌的丰度。该方法具有快速、高效、准确率高等优点。
1.4典型案例
Furuhata[8]对日本医院使用的自来水中栖息的甲基杆菌物种的分布和分离株的抗生素敏感性进行调查,根据16S rDNA部分序列的同源性对58株分离株进行物种鉴定。发现医院的自来水中存在大量的甲基杆菌属,其中也检出了嗜中温甲基杆菌。
1.5防治对策
日常生活中要注意饮用水安全,水烧开后饮用,医院中的患者尤其要注意,不直接饮用医院自来水,避免自来水中的嗜中温甲基杆菌感染免疫力低下的患者。此外,医院要注意应使用无菌水对医疗器械进行消毒。
参考文献
[1] Beck ET, Bateman AC, Maccoux D. Methylobacterium infection of an arthritic knee. JMM Case Rep, 2019, 6: e005173.
[2] Doerges L, Kutschera U. Assembly and loss of the polar flagellum in plant-associated methylobacteria. Naturwissenschaften, 2014, 101: 339-346.
[3] Barbeau J, Tanguay R, Faucher E et al. Multiparametric analysis of waterline contamination in dental units. Appl Environ Microbiol, 1996, 62: 3954-3959.
[4] 周庭银, 章强强. 临床微生物学诊断与图解 下 第4版. 上海: 上海科学技术出版社, 2017.
[5] Dworkin M, Falkow S, Rosenberg E et al. The Prokaryotes. Springer: New York, 2006.
[6] Szwetkowski KJ, Falkinham JO 3rd. Methylobacterium spp. as Emerging Opportunistic Premise Plumbing Pathogens. Pathogens, 2020, 9: 149.
[7] Kovaleva J, Degener JE, van der Mei HC. Methylobacterium and its role in health care-associated infection. J Clin Microbiol, 2014, 52: 1317-1321.
[8] Furuhata K, Kato Y, Goto K et al. Isolation and identification of methylobacterium species from the tap water in hospitals in Japan and their antibiotic susceptibility. Microbiol Immunol, 2006, 50: 11-17.
.png)
